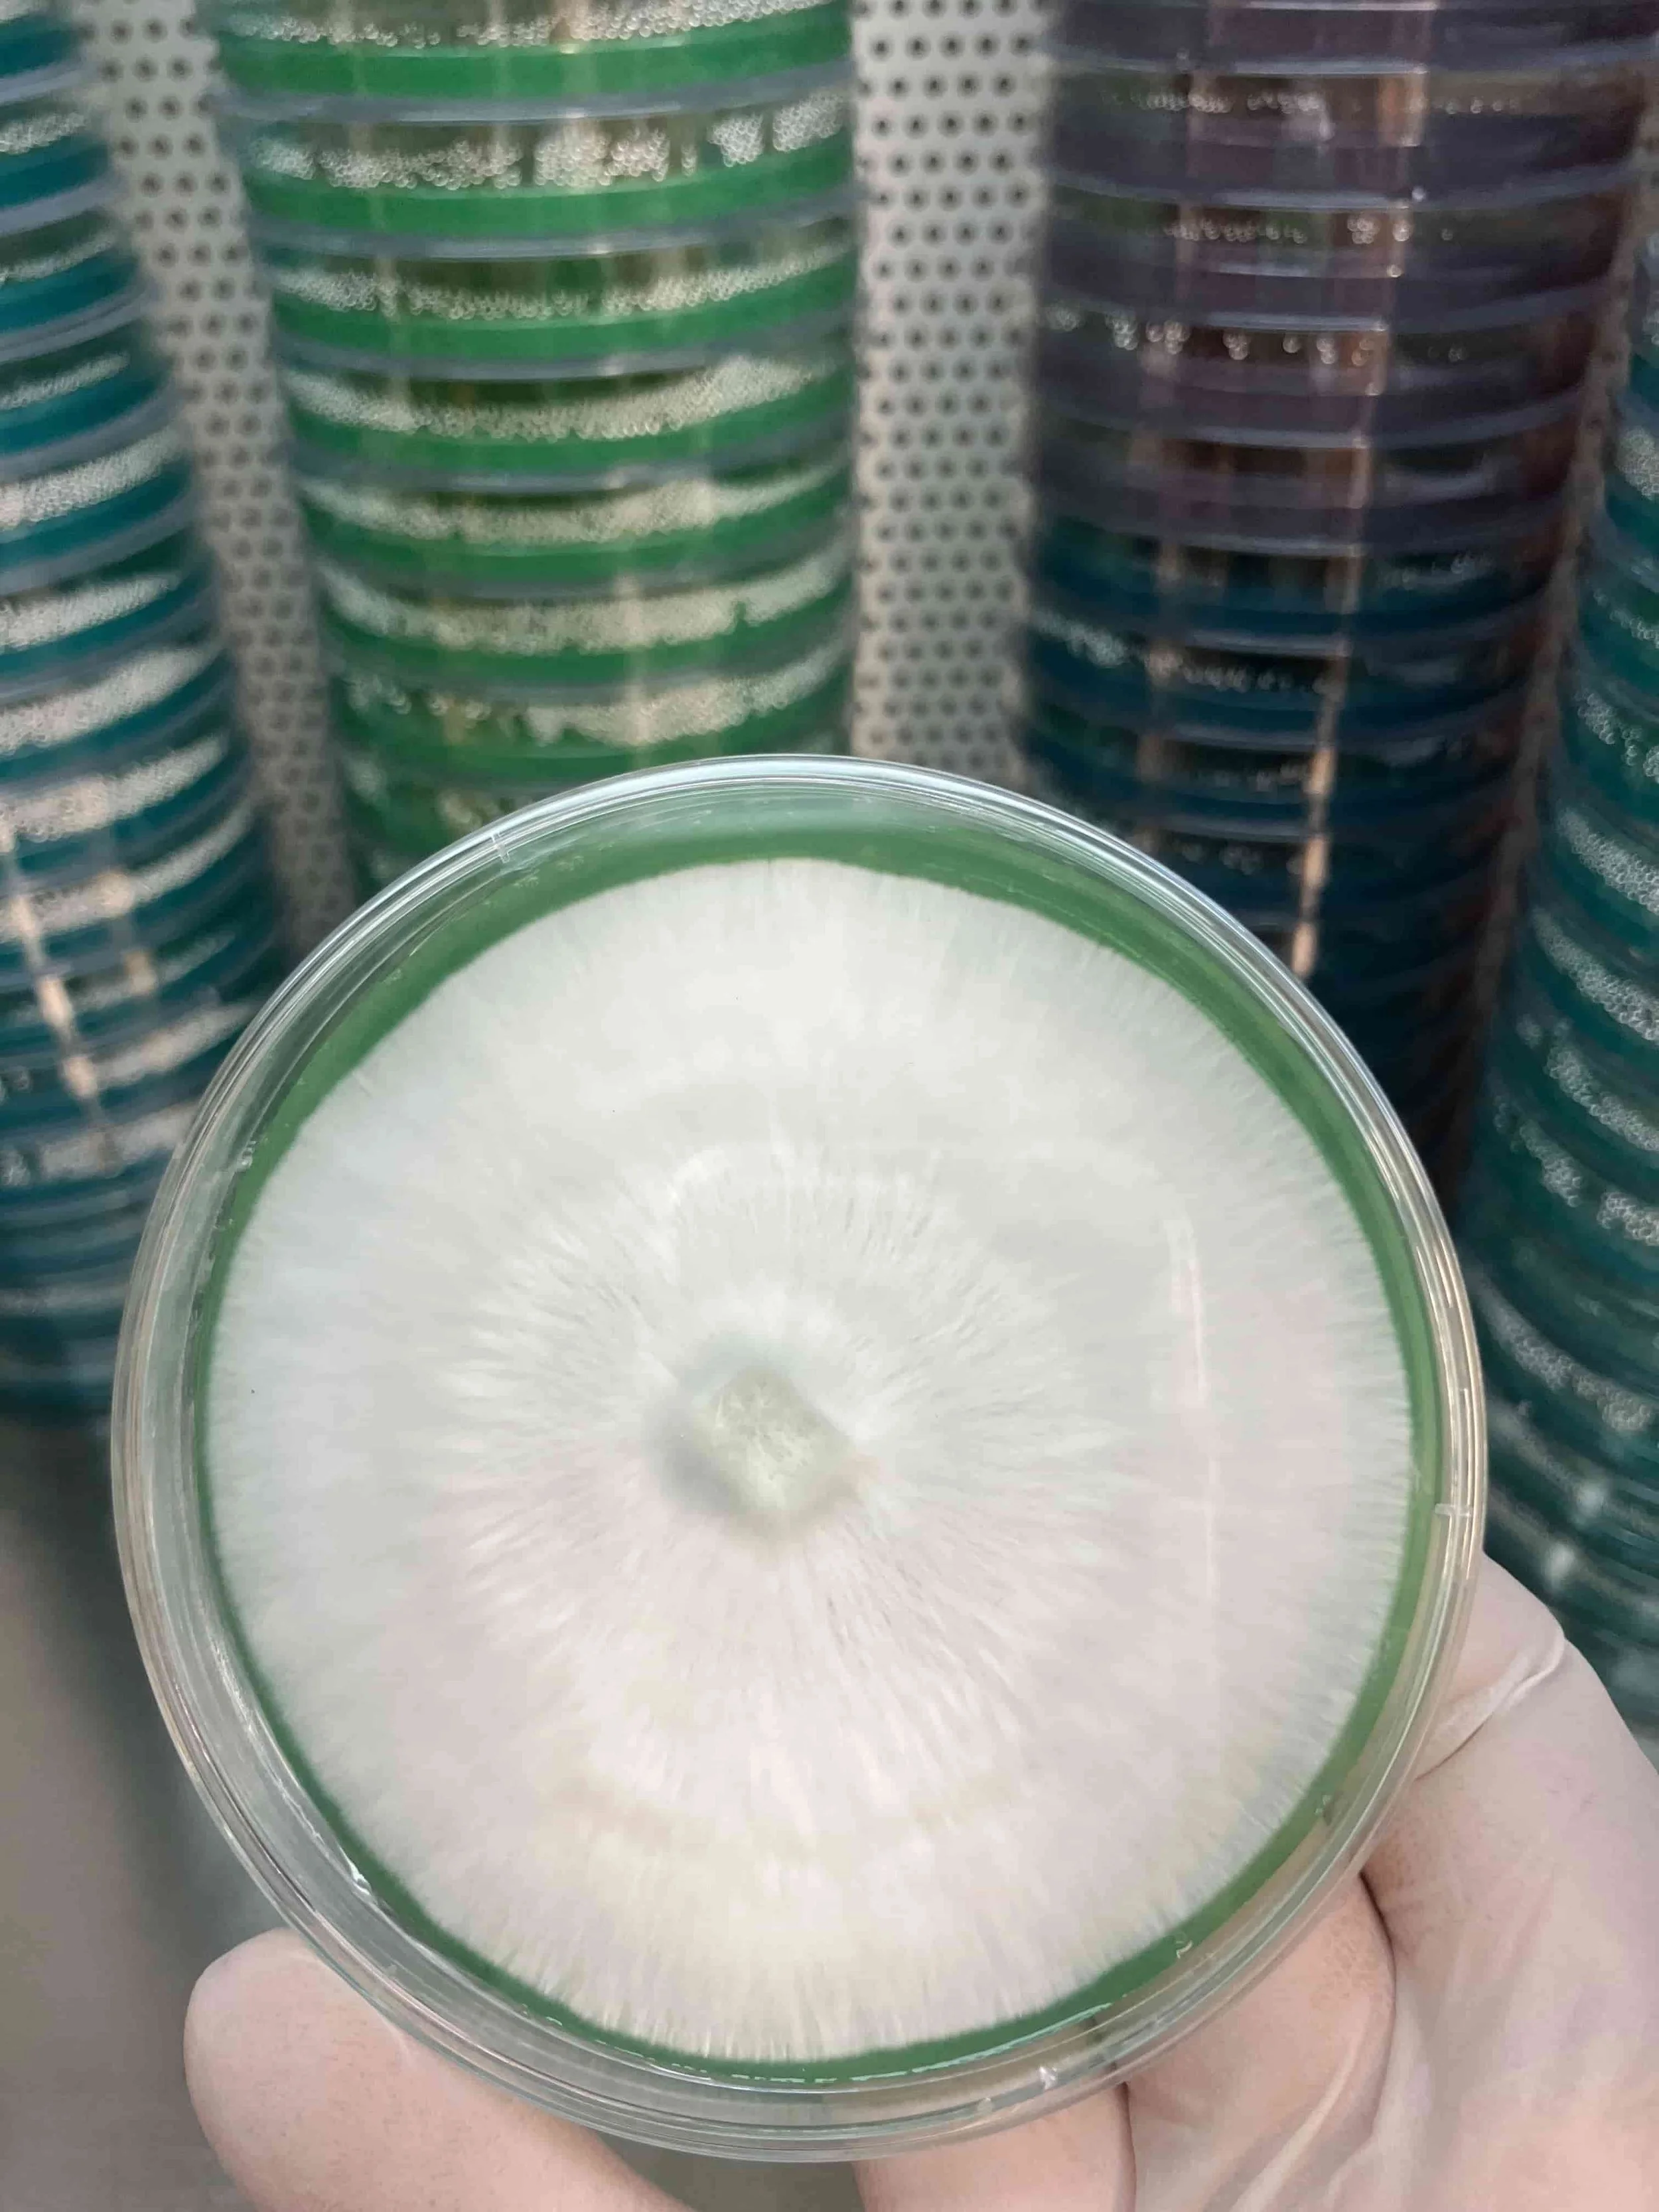

The Ultimate Guide to Mushroom Growing Supplies and Top Trends for 2025
Mushroom cultivation is booming, and whether you’re a home grower, a small-scale farmer, or an entrepreneur, 2025 is set to bring exciting advancements in mushroom growing supplies and techniques. From sustainable materials to cutting-edge technology, the world of mycology is evolving rapidly. At Merry Mushroom Maidens, we’re passionate about helping you grow your own fungi with ease and success. In this guide, we’ll break down the essential supplies you need to cultivate mushrooms and highlight the top trends shaping the industry in 2025. Let’s dive into the fascinating world of fungi!
Essential Mushroom Growing Supplies
To grow mushrooms at home or on a larger scale, you need the right tools and materials. Here’s a rundown of the must-have supplies for any mushroom grower:
1. Substrate (The Mushroom’s Food Source)
The substrate is the foundation of mushroom growth, providing nutrients for your fungi. Common substrates include straw, wood chips, sawdust, and composted manure, each suited to specific mushroom varieties. For example, oyster mushrooms thrive on straw, while shiitake prefer hardwood sawdust. Pre-mixed, sterilized substrate bags are a lifesaver for beginners, reducing the risk of contamination.
Pro Tip: Look for substrates tailored to your mushroom type, and ensure they’re properly pasteurized or sterilized to keep mold and bacteria at bay.
Masters Mix mushroom substrate is one of the most commonly used hardwood substrates used by mushroom growers, 50%Oak / 50% Soy.
2. Mushroom Spawn (The Seeds)
Spawn is the mycelium-inoculated material that jumpstarts your mushroom growth. Available in forms like grain, sawdust, or wooden plugs, spawn must match the mushroom species you’re growing. Oyster mushrooms often use grain spawn, while shiitake and lion’s mane work well with sawdust or plugs. High-quality spawn ensures faster colonization and better yields.
Pro Tip: Source spawn from reputable suppliers like Merry Mushroom Maidens to avoid weak or contaminated batches.
Mushroom Grain Spawn, mushroom grain spawn is the seed of the mushroom added to the mushroom substrate for colonization of mycelium. The most common method of inoculating mycelium into sterilized mushroom substrate.
3. Grow Bags or Containers
Grow bags with filter patches are popular for maintaining humidity and airflow while keeping contaminants out. They’re ideal for species like oyster, reishi, and pink oyster. Alternatively, trays, buckets, or logs can be used, depending on your setup. In 2025, biodegradable grow bags made from plant-based materials are gaining traction for their eco-friendliness, appealing to environmentally conscious growers.
Pro Tip: Choose containers based on your space and scale—grow bags for small setups, logs for outdoor shiitake, or trays for commercial production.
Mushroom grow bags with micron filter patches used for growing mushrooms at Merry Mushroom Maidens farm.
Pro Tip: Make sure to use the right filter patch for the strains of mushrooms you are growing for proper airflow for mycelium colonization. Only use or purchase mushroom grow bags produced by a reputable manufacturer. Our experience with cheap mushroom grow bags was contamination and loss of mushroom substrates. The cost of replacing substrates was a much greater loss and waste at the end. Merry Mushroom Maidens only uses Unicorn mushroom grow bags for the proper sterilization and cultivation of our mushrooms.
4. Sterilization and Hygiene Tools
Cleanliness is non-negotiable in mushroom cultivation. Contamination can ruin your crop, so invest in tools like pressure cookers or autoclaves for sterilization of substrates, alcohol sprays, gloves, and face masks. For serious growers, a laminar flow hood provides a sterile workspace, though it’s a bigger investment. Pro Tip: A basic hygiene kit with alcohol wipes, disposable gloves, and a small spray bottle is enough for beginners to maintain a clean workspace.
Commercial autoclave for sterilizing mushroom grains and substrates.
5. Environmental Control Equipment
Mushrooms are picky about their environment, needing specific humidity, temperature, and light conditions to thrive. A hygrometer and thermometer are essential for monitoring, while humidifiers or misting systems keep humidity at 80-95% for most species. Fans promote air circulation to prevent mold, and grow tents or shelving units help create a controlled space. In 2025, compact, affordable grow tents with built-in ventilation are trending for urban growers.
Pro Tip: If you’re on a budget, start with a manual spray bottle for misting and a basic fan, but consider upgrading to a humidifier or fogger for consistent results.
6. Grow Kits (For Beginners)
For those just starting out, all-in-one mushroom grow kits are a fantastic way to dip your toes into mycology. These kits come with pre-inoculated substrate, spawn, and step-by-step instructions, making it easy to grow varieties like oyster, lion’s mane, or pink oyster. They’re perfect for hobbyists, educators, or even as unique gifts.
Pro Tip: Explore Merry Mushroom Maidens’ selection of beginner-friendly grow kits to start growing with confidence.
Merry Mushroom Maidens all-in-one mushroom grow kit (for beginners).
Top Mushroom Growing Trends for 2025
The mushroom industry is evolving fast, driven by sustainability, health-conscious consumers, and technological advancements. Here are the top trends to watch in 2025 that will shape how you grow and what you grow:
1. Eco-Friendly and Sustainable Supplies
Sustainability is at the forefront of mycology, with growers embracing biodegradable grow bags, recycled substrates like coffee grounds or coconut coir, and compostable packaging. Suppliers are responding with carbon-neutral products to meet demand from eco-conscious consumers. At Merry Mushroom Maidens, we’re proud to offer sustainable options to help you grow with the planet in mind.
Why It Matters: Eco-friendly supplies reduce environmental impact and align with the growing trend of regenerative agriculture.
2. Functional and Exotic Mushrooms on the Rise
While oyster and shiitake remain staples, functional mushrooms like lion’s mane, reishi, cordyceps, and turkey tail are surging in popularity for their potential health benefits, including improved focus, immunity, and stress relief. In 2025, expect spawn, substrates, and kits for exotic varieties like pink oyster, king trumpet, and blue oyster to dominate the market.
Why It Matters: Health-driven demand makes these mushrooms a profitable niche for growers and a draw for wellness-focused consumers.
Merry Mushroom Maiden’s Fresh Antler Reishi
3. Smart Technology for Precision Cultivation
Technology is revolutionizing mushroom growing. Affordable smart sensors that monitor humidity, temperature, and CO2 levels are becoming standard, even for home setups. Automated grow systems with app-controlled misting, lighting, and ventilation are also gaining traction, especially for commercial growers. In 2025, look for budget-friendly smart kits designed for hobbyists.
Why It Matters: Precision tools boost yields, reduce labor, and make growing easier for all skill levels.
The Inkbird humidity control system provides precise monitoring and adjustment of humidity levels, ensuring optimal conditions for mushroom cultivation. With its user-friendly interface and reliable performance, it effectively supports the growth and maintenance of mushrooms in various environments.
A fogger head connects to the Inkbird control by attaching the control's output to the fogger's input port, ensuring optimal humidity levels for your mushroom cultivation environment. This setup allows the Inkbird temperature and humidity controller to activate the fooger head based on pre-set conditions, automating the moisture regulation process. ProTip:Researching the preferred humidity levels for each mushroom strain is essential for optimizing growth and yield. Different strains have specific moisture requirements that can significantly impact their development, so understanding these needs will help create ideal growing conditions.
4. Urban and DIY Mushroom Farming
With urban farming on the rise, city dwellers are growing mushrooms in apartments, balconies, and community spaces. Compact grow kits, vertical shelving, and space-saving supplies are trending to meet this demand. Online courses, mycology workshops, and community-driven clubs are also popping up to support urban growers.
Why It Matters: Urban farming promotes local food production and makes mycology accessible to a broader audience.
Shiitake mushroom substrate colonizing on vertical shelving, used for space-saving to meet the demand for commercial mushroom growing.
5. Mycelium-Based Innovations
Mycelium, the root-like network of fungi, is being used for more than just food. In 2025, expect growers to experiment with mycelium for biodegradable packaging, vegan leather, and even construction materials like fungal bricks. Suppliers may offer DIY mycelium kits for these applications, blending cultivation with sustainability.
Why It Matters: Mycelium’s versatility opens new revenue streams for growers and positions fungi as a leader in eco-innovation.
Underground Mycelium Network
How to Get Started with Mushroom Growing in 2025
Ready to jump into the world of mycology? Whether you’re growing for fun, health, or profit, starting is easier than you think. Follow these steps to set yourself up for success:
• Pick Your Mushroom: Start with beginner-friendly varieties like oyster or lion’s mane.
• Choose Your Supplies: Match substrate and spawn to your mushroom type, and invest in basic hygiene tools.
• Set Up Your Space: Create a clean, humid area with good ventilation, using a grow tent or shelving.
• Monitor and Maintain: Check humidity and temperature daily, mist as needed, and keep contaminants out.
• Harvest and Enjoy: Watch your mushrooms flourish and savor the fruits of your labor!
Fresh harvested Chestnut mushrooms from Merry Maidens Mushroom farm.
At Merry Mushroom Maidens, we’ve got everything you need to get started, from high-quality substrates and spawn to eco-friendly grow bags and mushroom growing supplies. Our curated selection is designed to make your growing journey seamless, whether you’re a newbie or a seasoned mycologist.
Merry Mushroom Maidens Hunters Washington, 99137
Why Choose Merry Mushroom Maidens?
We’re more than just a supplier—we’re your partner in mycology. Our commitment to quality, sustainability, and education sets us apart. We offer:
• Premium Supplies: Sourced for reliability and performance.
• Eco-Conscious Options: Helping you grow with the planet in mind.
• Expert Support: Tips, guides, and community resources to ensure your success.
Join the Fungal Revolution with Merry Mushroom Maidens
A bright Magic future for cultivating Mushrooms!
The future of mushroom growing is bright, and 2025 is the perfect time to dive in. Whether you’re cultivating for flavor, health, or innovation, the right supplies and trends can set you up for success. Explore our collection at Merry Mushroom Maidens to find everything you need to grow your own fungi. Have questions or need advice? Drop a comment below, join our newsletter for exclusive tips, or contact our team—we’re here to help you grow!
What’s your favorite mushroom to grow, and how are you preparing for 2025? Share your thoughts and let’s keep the mycology conversation going!